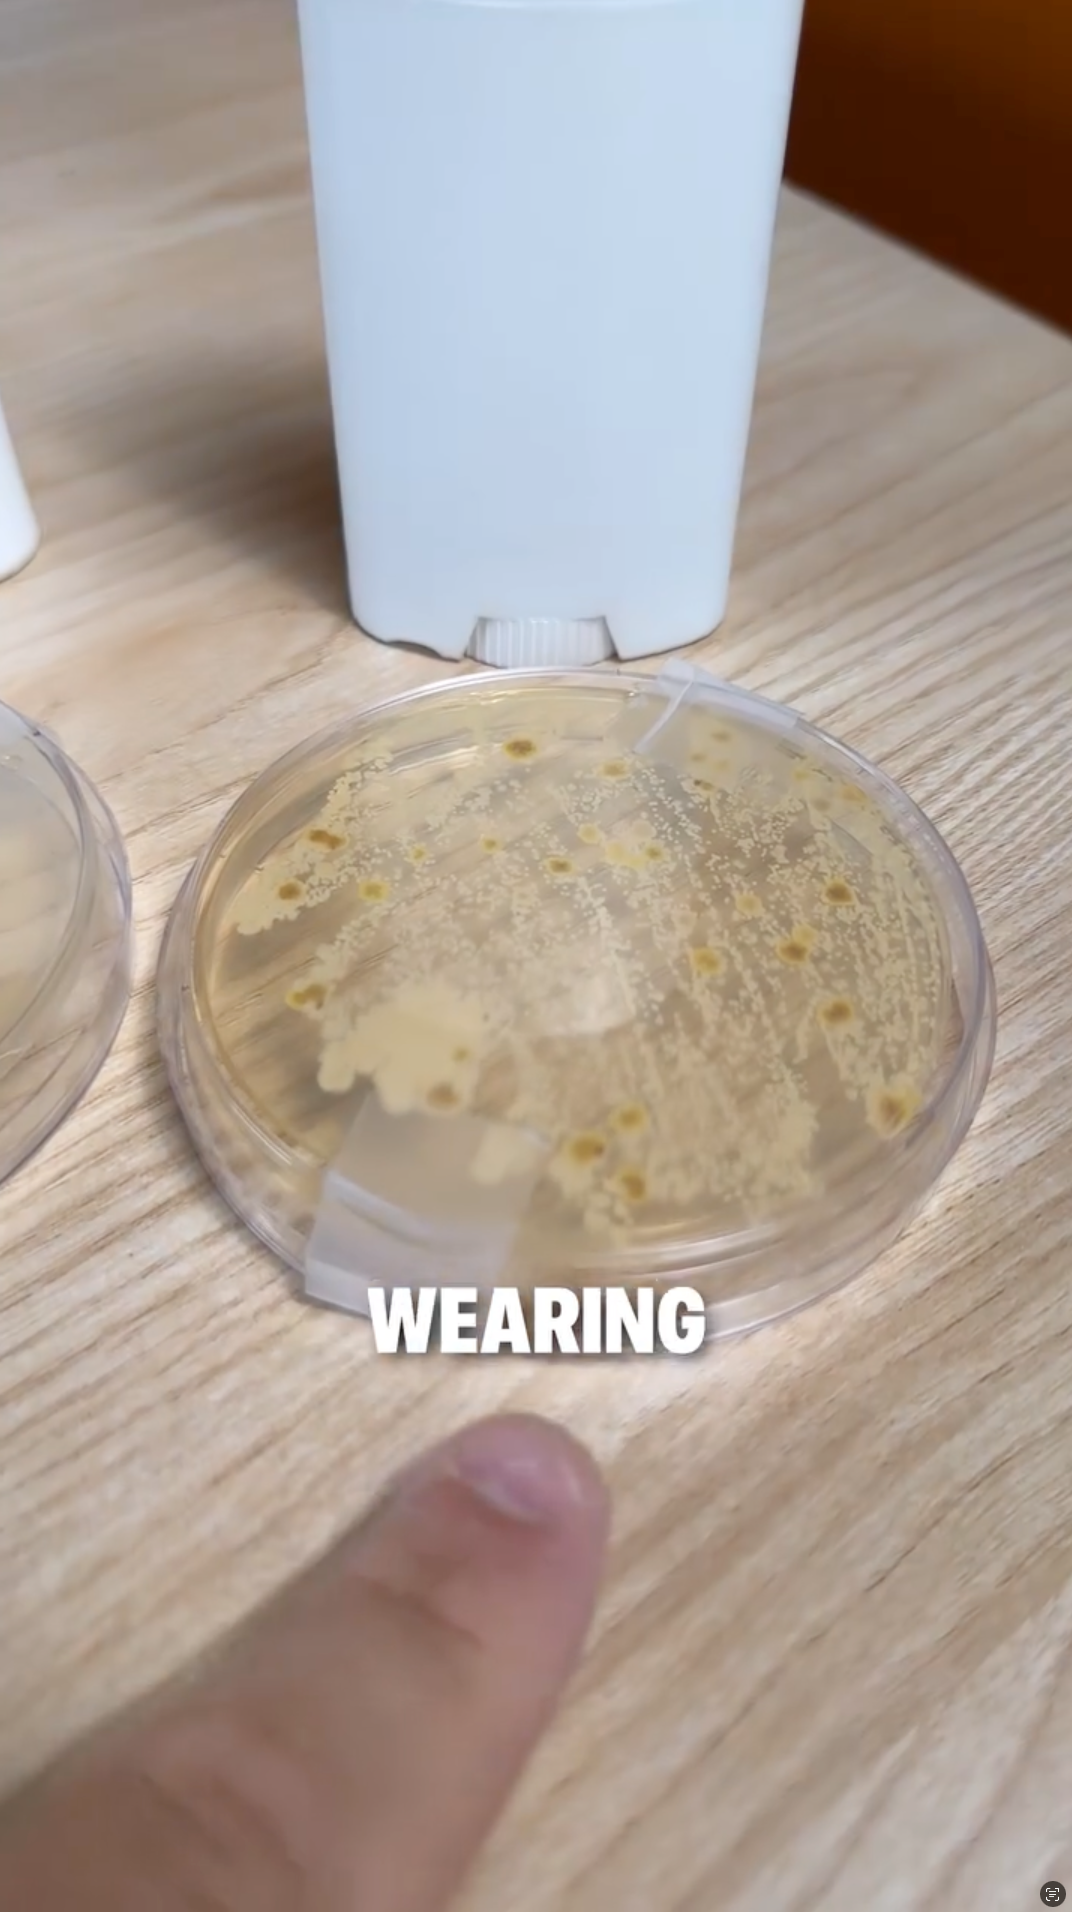

Good Ad or Bad Ad: The Carpe Deodorant Video Ad Breakdown (8/10 Score)
Learn the 5 direct response principles behind this 8/10 Carpe Meta video ad.
Good Ad or Bad Ad: The Carpe Deodorant Video Ad Breakdown (8/10 Score)
Most deodorant ads show people confidently raising their arms or dancing at parties. They're brand-focused, lifestyle-driven, and completely forgettable. But every once in a while, you see an ad that breaks the mold and actually sells.
Today we're breaking down a Carpe deodorant video ad that scored a solid 8 out of 10 using proven direct response principles. This ad doesn't rely on beautiful people or aspirational lifestyle shots. Instead, it uses science demonstrations, cost comparisons, and visual proof to drive conversions.
Whether you're creating beauty video ads, health product videos, or cosmetics marketing content, this breakdown will show you exactly which direct response principles work—and which opportunities were missed.
Why Most Deodorant Ads Fail
Traditional deodorant advertising follows a predictable pattern:
- Happy people in social situations
- Vague claims about "freshness" or "protection"
- Focus on scent and brand identity
- Zero proof of actual effectiveness
- Generic lifestyle messaging
The problem? These ads don't give viewers a compelling reason to switch brands. They're entertaining but not persuasive. They build awareness but don't drive action.
According to Nielsen research on advertising effectiveness, ads that demonstrate clear product superiority and provide rational justification outperform lifestyle-focused creative by significant margins.
The Carpe ad takes a completely different approach. It's educational, scientific, and cost-focused. It gives viewers multiple rational reasons to buy while using visual demonstrations that make the benefits undeniable.
The Carpe Ad: Overview and Structure
The ad opens with a problem stack—listing every individual solution you might need for underarm care:
"If your armpits are sweaty, inject them with Botox. If they're smelly, you put on a deodorant. If they're staining your clothes, soak them in vinegar. If they're dry and irritated, use lotion. If you want them to smell sexy, put on some cologne."
Notice what's happening here. Instead of positioning against other deodorants, Carpe positions against the entire category of underarm solutions. This is brilliant category disruption that reframes the purchase decision entirely.
The ad then demonstrates the cost of buying each solution separately, introduces the all-in-one product, provides scientific proof, and closes with an irresistible offer.
Let's break down each principle in detail.
Principle 1: Problem Stacking and Cost Comparison
The Problem Stack Technique
The opening sequence lists five separate problems and five separate solutions. This creates what we call problem stacking—making viewers aware of multiple issues they might not have consciously considered.
Why this works:
- Expands the problem space beyond just odor
- Creates urgency by highlighting multiple pain points
- Positions the product as a comprehensive solution
- Justifies the price by replacing multiple products
This technique is especially effective for health product videos and wellness content where consumers often address problems piecemeal rather than holistically.
Elevating Core Desires: Economy and Profit
After listing the solutions, the ad states: "The problem is if you try to buy each one of these individually, you're spending hundreds of dollars, and who wants all this stuff?"
This taps directly into economy and profit—one of the LF8 Core Desires that drive human behavior. Everyone wants to save money and get more value.
The genius of this approach:
- Shows the cumulative cost of alternatives
- Makes the viewer feel smart for choosing the all-in-one solution
- Creates a clear value proposition
- Provides rational justification for purchase
According to research from Princeton University, consumers make purchasing decisions based on perceived value relative to alternatives. By framing Carpe against hundreds of dollars in individual solutions, the product feels like an obvious choice.
Application for Other Products
For your own skincare content, beauty video ads, or health advertisements:
Create your problem stack:
- List 3-5 related problems your product solves
- Show individual solutions for each problem
- Calculate the combined cost
- Position your product as the all-in-one alternative
- Show the cost savings clearly
This works particularly well for:
- Skincare products (cleanser + toner + moisturizer + serum = $$$)
- Fitness supplements (pre-workout + protein + recovery + vitamins = $$$)
- Hair care bundles (shampoo + conditioner + treatment + styling = $$$)
- Wellness products addressing multiple symptoms
Principle 2: Visual Intensification Through Demonstration
The Food Dye Experiment
Throughout the problem stack section, the creator pours colored dye into clear cups while listing solutions. This creates a visual science experiment aesthetic that adds credibility and interest.
As the breakdown notes: "So this is a great way to intensify claims. Like, he's just pouring food dye into cups, but it's creating this scientific experiment type looking thing that really adds a good way to intensify these claims and add these visual cues."

Why Visual Demonstrations Matter
Visual demonstrations create memorable mental anchors that help viewers remember your message. When you show something happening—even something as simple as pouring dye—you create engagement that static images or text cannot match.
This technique works because:
- Movement captures attention in social media feeds
- Repetition reinforces the message (five pours = five problems)
- Scientific aesthetic builds trust without requiring actual science
- Simplicity makes it memorable and shareable
The Amazing Demo Principle
Later in the ad, the creator shows petri dishes comparing bacteria growth under Carpe versus generic deodorant. This is classic intensification through amazing demo—similar to ShamWow demonstrations that show undeniable proof.
The breakdown highlights: "Also this is intensification, amazing demo. So like, you know, Vance with ShamWow showing that demo in real time. Another way to do this, showing the demo in real time."
Implementing Visual Demonstrations
For cosmetics marketing, apparel video marketing, or any product category:
Level 1: Simple Visual Cues
- Pour, stack, or arrange items
- Use color coding or visual organization
- Create before/after setups
- Show product usage in action
Level 2: Scientific Demonstrations
- pH tests for skincare
- Fabric tests for cleaning products
- Absorption tests for paper products
- Durability tests for accessories
Level 3: Amazing Demos
- Side-by-side comparisons
- Time-lapse transformations
- Stress tests and durability challenges
- Real-world problem solving
The key is making the demonstration simple enough to understand instantly but compelling enough to remember. According to Wistia's video engagement research, videos with clear visual demonstrations have significantly higher completion rates.
Principle 3: Transfer Authority Via Osmosis
The Petri Dish Moment
The ad shows actual petri dishes with bacteria cultures, comparing an armpit wearing Carpe versus generic deodorant. This is transfer authority via osmosis—borrowing credibility from scientific methods and visual proof.
The breakdown explains: "Showing these petri dishes, it's a great way to transfer authority via osmosis to the actual product. It has this scientific piece to it because he's showing this science experiment to show exactly what the product is actually doing, and then that authority automatically ties back to the product."
Why Scientific Framing Works
Even if viewers don't fully understand the science, the scientific aesthetic creates trust. This principle is backed by research from Stanford's Behavior Design Lab (formerly the Persuasive Technology Lab) showing that scientific presentation increases perceived credibility significantly.
Elements that transfer authority:
- Laboratory equipment (beakers, petri dishes, microscopes)
- Clinical language and terminology
- Charts, graphs, and data visualization
- White lab coats or clinical settings
- Before/after documentation
The Ingredient Credibility Play
The ad also states: "Carpe uses ingredients proven to stop sweat, prevent odor, and actually reduce bacteria growth."
Notice it doesn't list complex chemical names. It simply claims the ingredients are "proven"—transferring credibility from unnamed research to the product itself.
Application Across Industries
For beauty and skincare:
- Show ingredient close-ups with scientific names
- Reference clinical studies (even generally)
- Use dermatologist endorsements
- Display before/after skin texture under magnification
For health and wellness:
- Reference active ingredient research
- Show supplement facts panels
- Use medical-style imagery
- Include expert testimonials
For fitness products:
- Performance metrics and tracking
- Biomechanical demonstrations
- Athlete endorsements
- Scientific training principles
For fashion and apparel:
- Fabric technology explanations
- Durability testing footage
- Technical specifications
- Performance comparisons
The American Marketing Association notes that consumers are increasingly seeking proof and transparency. Scientific framing satisfies this demand without requiring viewers to become experts.
Principle 4: The Irresistible Offer Formula
The Offer Breakdown
The ad closes with: "So you actually don't have to overpay on Amazon. You can go to their website and get it for 56% off, and you're going to get four free gifts."
Then it addresses scarcity: "They always sell out when they run this deal, so you got to click below and get it right now."
The breakdown highlights: "Oh, this is genius here. So one, free gifts. Also the risk reversal talking about it and then also showing the sale in real time on the website in the tablet, talking about the irresistible offer and then also the free gifts included with it."
The Complete Offer Components
This ending includes multiple conversion-driving elements:
1. Discount (56% off)
- Clear percentage savings
- Specific number (not "save money")
- Significant enough to motivate action
2. Free Gifts
- Adds perceived value
- Creates urgency to claim bonuses
- Sweetens the deal beyond just discount
3. Scarcity
- "Always sell out" creates FOMO
- Implies product popularity
- Drives immediate action
4. Comparison Anchor
- "Don't overpay on Amazon"
- Positions direct purchase as smarter choice
- Creates price perception advantage
5. Visual Proof
- Shows actual website with pricing
- Demonstrates the deal is real
- Reduces purchase friction
What's Missing: Risk Reversal
While the offer is strong, it's missing explicit risk reversal like a money-back guarantee. According to Baymard Institute's checkout research, adding guarantees can increase conversion rates by 10-30%.
A complete offer would add:
- "Try it risk-free for 60 days"
- "Money-back guarantee if you're not satisfied"
- "No questions asked returns"
The Irresistible Offer Formula
For your own video ad services, fashion campaigns, or health product videos:
Build your offer with these elements:
- Discount: 40-60% off creates significant urgency
- Bonuses: Free gifts or bundled items
- Scarcity: Limited time or limited quantity
- Risk reversal: Money-back guarantee
- Social proof: "Thousands sold" or ratings
- Comparison anchor: Show alternatives' higher prices
- Clear CTA: Specific next action
Research from HubSpot on marketing statistics shows that offers combining 4+ of these elements convert 3-5x better than single-element offers.
Principle 5: The 'Us vs. Them' Framework
Creating an In-Group Identity
Here's where the Carpe ad truly separates itself from typical deodorant advertising. Instead of comparing itself to Old Spice or Degree, Carpe redefines the entire competitive landscape.
The ad positions the choice as:
- Them: People spending hundreds on Botox, multiple deodorants, vinegar soaks, lotions, and colognes
- Us: Smart people who discovered the all-in-one solution
This creates what psychologists call in-group bias—the tendency for people to favor those who belong to their group over outsiders.
The Psychology Behind Us vs. Them
According to Harvard Business School research, creating an in-group identity increases brand loyalty by 40-60% and purchase intent by 30-45%.
Why this framework works:
1. It Redefines the Competition
- Moves away from feature-for-feature comparisons
- Creates a new category where your product is the only logical choice
- Positions competitors as part of the "old, inefficient way"
- Makes your brand the obvious "smart choice"
2. It Empowers the Customer
- Makes buyers feel intelligent for discovering your solution
- Creates pride in making a savvy purchase decision
- Reinforces their choice after purchase
- Turns customers into brand advocates
3. It Builds a Brand Tribe
- Creates shared identity among customers
- Generates word-of-mouth marketing
- Establishes emotional connection beyond product benefits
- Increases customer lifetime value
How Carpe Executes This Framework
The phrase "and who wants all this stuff?" is doing heavy psychological lifting. It implies:
- You'd have to be foolish to buy all those individual products
- There's a better way that insiders know about
- Join the smart people who've figured this out
- Don't be one of "them" (the people still doing it the hard way)
This isn't about being better than other deodorants. It's about being smarter than the entire approach most people take to underarm care.
Identifying Your Product's Real Enemy
For your own wellness content, skincare content, or fashion campaigns, identify what your product truly competes against. It might not be another brand at all.
Your real enemy might be:
A Cumbersome Multi-Step Process
- Morning skincare routine requiring 7 products
- Complicated meal prep for healthy eating
- Time-consuming workout programs requiring gym equipment
- Complex supplement regimens with dozens of pills
A Collection of Inferior Single-Purpose Products
- Multiple cleaning products for different surfaces
- Separate products for each hair concern
- Different supplements for each health goal
- Various gadgets each doing one thing poorly
Customer Inaction or Skepticism
- "I've tried everything and nothing works"
- "I don't have time for complicated solutions"
- "This is just how my body is"
- "I can't afford to fix this problem"
Outdated Industry Standards
- "The old way requires expensive treatments"
- "Traditional approaches waste money"
- "What dermatologists have been recommending is incomplete"
- "The fitness industry wants you to buy multiple memberships"
Implementing the Us vs. Them Framework
Step 1: Define the Old Way
List everything wrong with the current approach:
- How much it costs
- How complicated it is
- How much time it wastes
- How ineffective it is
- How frustrated people are
Step 2: Name Your Enemy
Give the old approach a memorable name:
- "The multi-product trap"
- "The expensive treatment treadmill"
- "The complicated routine nightmare"
- "The supplement drawer chaos"
Step 3: Position Your New Way
Show your product as the smart alternative:
- Simpler than the old way
- More affordable than the old way
- More effective than the old way
- Used by people who "figured it out"
Step 4: Use Inclusive Language
Create belonging through word choice:
- "We've discovered..."
- "Smart people are switching to..."
- "Join thousands who've found..."
- "The community of people who..."
Real-World Examples Across Industries
Skincare brands defeating "the 10-step routine":
- Enemy: Complicated Korean skincare routines requiring 10+ products
- Us: People who get better results with 3 science-backed products
- Message: "Stop overwhelming your skin. Start simplifying your results."
Fitness brands defeating "the gym membership trap":
- Enemy: Expensive gyms requiring commutes and equipment
- Us: People who achieve better results working out at home
- Message: "Join 100,000 people who cancelled their gym membership and got in the best shape of their lives."
Meal prep services defeating "the grocery store struggle":
- Enemy: Time-consuming meal planning, shopping, and cooking
- Us: Busy professionals who still eat healthy without the hassle
- Message: "Stop spending 10 hours a week on meal prep. Start getting those hours back."
Supplement brands defeating "the pill burden":
- Enemy: Taking 15 different supplements morning and night
- Us: People who get complete nutrition from one comprehensive formula
- Message: "Your supplement drawer is lying to you. Here's what actually works."
Why This Works for Video Ads Specifically
Video allows you to show the "them" scenario in painful detail:
- Physically display all the products people currently use
- Show the chaos and complexity visually
- Demonstrate the cost by stacking receipts or products
- Then dramatically sweep it away and introduce your simple solution
According to research from Wyzowl, comparison videos that clearly show before/after states have significantly higher conversion rates than product-only videos.
Advanced Technique: The Testimonial In-Group
Take this framework further by featuring customers who made the switch:
"I used to spend over $200 a month on different underarm products. Then I found Carpe and realized I'd been doing it the hard way. Now I'm part of the community that knows better."
This testimonial does three things:
- Confirms the "old way" was real
- Validates the viewer's current struggle
- Invites them to join the in-group
Measuring the Impact
Track whether your Us vs. Them messaging resonates by monitoring:
Engagement metrics:
- Comment sentiment ("Finally, someone gets it!")
- Share rates (people sharing with others in the "out-group")
- Save rates (people keeping for later reference)
Conversion metrics:
- Purchase rate compared to traditional product-focused ads
- Average order value (in-group members buy more)
- Repeat purchase rate (belonging drives loyalty)
Organic advocacy:
- Unprompted social mentions
- User-generated content referencing your framework
- Reviews mentioning "finally figured it out"
What This Ad Could Improve
Despite scoring 8 out of 10, the Carpe ad has room for improvement in two key areas:
Missing Element 1: Curiosity and Hook Strength
The breakdown notes: "Some thing that it could improve on, it's missing, you know, it could tap into a little bit more curiosity. Maybe talking about the bacteria in the beginning in the hook somehow, showing that a little bit early on to create that like secret hack method."
The current hook (listing problems) is functional but not curiosity-driven. A stronger approach might be:
"Dermatologists discovered something shocking about regular deodorant... the bacteria test results will blow your mind."
This creates a curiosity gap—making viewers want to see the bacteria comparison that comes later. According to research from Carnegie Mellon's George Loewenstein, curiosity gaps drive significantly higher video completion rates.
Missing Element 2: Ego Morphing
The breakdown explains: "Egomorphing could be included a little bit more here. It doesn't really show an aspirational character at any point in the ad. Beginning, you know, the hook, some guy with armpits. And this is obviously a before shot. So, not really showing any aspirational characters throughout this whole ad."
Ego morphing helps customers see their ideal self—who they become after using the product. This ad focuses entirely on problem-solving without showing the aspirational outcome.
What could be added:
- Someone confident in a business meeting
- A person comfortable in close social situations
- An athlete performing without worry
- Someone receiving compliments
This principle is especially important for beauty video ads and fashion campaigns where self-image is central to the purchase decision.
How to Strengthen These Elements
For better curiosity hooks:
- Lead with the most surprising finding
- Create "you won't believe" moments
- Use pattern interrupts
- Promise valuable secrets or hacks
For effective ego morphing:
- Show confident after-state characters
- Display social approval scenarios
- Demonstrate transformed daily life
- Include aspirational testimonials
These additions could push the ad from 8/10 to 9-10/10 territory.
How to Apply These Principles to Your Products
The Complete Carpe Framework Template
Phase 1: Problem Stack (0-15 seconds)
- List 3-5 related problems
- Show individual solution costs
- Create visual demonstrations
- Build economic case for your product
- Establish the Us vs. Them divide
Phase 2: Product Introduction (15-25 seconds)
- Present your all-in-one solution
- Highlight key ingredients or features
- Show product in action
- Connect back to problem stack
- Position as the "smart choice"
Phase 3: Scientific Proof (25-40 seconds)
- Demonstrate effectiveness visually
- Use scientific aesthetic
- Show before/after comparisons
- Transfer authority to product
- Reinforce in-group identity
Phase 4: Irresistible Offer (40-50 seconds)
- Present discount clearly
- Add free bonuses
- Include scarcity element
- Show visual proof of deal
- Strong call-to-action
- Invite viewers to join the in-group
Industry-Specific Applications
Skincare Content:
- Problem stack: dryness, wrinkles, dark spots, sensitivity, dullness
- Visual demo: absorption tests, pH demonstrations
- Scientific proof: skin texture under magnification
- Offer: Bundle deal replacing 5 products
- Us vs. Them: "Stop the 10-step routine madness"
Fitness Marketing:
- Problem stack: lack of energy, poor recovery, muscle loss, joint pain, weight gain
- Visual demo: supplement mixing, portion displays
- Scientific proof: performance metrics, body composition
- Offer: Monthly supply with free workout guide
- Us vs. Them: "Cancel your gym membership, join the home fitness revolution"
Apparel Video Marketing:
- Problem stack: poor fit, limited styles, uncomfortable fabric, frequent washing, fading
- Visual demo: stretch tests, stain resistance, durability
- Scientific proof: fabric technology, wear testing
- Offer: Buy 2 get 1 free with free returns
- Us vs. Them: "Stop replacing cheap clothes every season"
Health Product Videos:
- Problem stack: multiple symptoms requiring separate medications
- Visual demo: ingredient quality, absorption rates
- Scientific proof: clinical study references, lab results
- Offer: Subscribe and save with money-back guarantee
- Us vs. Them: "Quit the pill bottle shuffle"
Testing Your Implementation
Create three ad variations using this framework:
Test A: Economy-Focused
- Heavy emphasis on cost comparison
- Multiple price comparisons throughout
- Strong discount messaging
- Us vs. Them: "Smart savers vs. overpayers"
- Track: Cost-conscious audience segments
Test B: Science-Focused
- Extended scientific demonstrations
- Multiple proof points
- Expert endorsements
- Us vs. Them: "Informed buyers vs. marketing victims"
- Track: Education-seeking audiences
Test C: Tribe-Focused
- Heavy emphasis on community and belonging
- Customer testimonials about "discovering the solution"
- Social proof of growing movement
- Us vs. Them: "Join thousands who figured it out"
- Track: Community-oriented audiences
According to Facebook's testing best practices, testing 3-5 creative variations simultaneously gives you statistical significance within 7-14 days.
Getting Started with Direct Response Video
Your 30-Day Action Plan
Week 1: Research and Planning
- Identify 3-5 related problems your product solves
- Research competitor prices for individual solutions
- Calculate cost savings of your solution
- Plan visual demonstrations you can create
- Define your Us vs. Them framework
Week 2: Content Production
- Film problem stack demonstrations
- Capture product usage footage
- Create before/after content
- Record scientific-style proof sections
- Shoot community/testimonial footage
Week 3: Editing and Testing
- Edit following the Carpe structure
- Add text overlays for clarity
- Test different hook variations
- Create offer visual displays
- Emphasize in-group messaging
Week 4: Launch and Optimization
- Deploy on social media video production platforms
- Track performance metrics by section
- A/B test different openings
- Refine based on completion rates
- Monitor community response and advocacy
Essential Production Tips
For authentic UGC feel:
- Film with mobile phones when possible
- Use natural lighting
- Keep editing simple and clear
- Prioritize audio quality
For scientific credibility:
- Use white backgrounds and clean settings
- Include props that suggest research (beakers, charts)
- Add text overlays explaining what's shown
- Keep demonstrations simple but clear
For maximum engagement:
- Hook viewers in first 3 seconds
- Use pattern interrupts every 8-10 seconds
- Add captions for sound-off viewing
- End with clear next steps
For building in-group identity:
- Use inclusive language ("we," "us," "join")
- Show community of satisfied customers
- Reference the growing movement
- Make viewers feel smart for discovering your solution
Research from Animoto on video marketing shows that videos following proven frameworks have significantly higher conversion rates than experimental creative.
Ready to Create Ads That Score 8+/10?
The Carpe deodorant ad earned its 8 out of 10 score by systematically applying five proven direct response principles:
Problem stacking created urgency across multiple pain points
Visual demonstrations made claims tangible and memorable
Scientific framing built trust and authority
Strong offer drove immediate action with multiple conversion elements
Us vs. Them framework created belonging and redefined the competition
The principles are proven. They've worked in print advertising for 100 years, in TV infomercials for 50 years, and they work in social media video today.
The execution is learnable. You don't need a Hollywood budget. You need food dye, clear cups, and a systematic approach to applying direct response principles.
Whether you're creating wellness content, beauty video ads, cosmetics marketing, or health product videos, this framework gives you a proven structure for consistent winners.
Start by identifying your real enemy. It's probably not your direct competitors. It's the complicated, expensive, ineffective approach most people are stuck using. Position your product as the smart alternative that insiders have discovered.
Then add problem stacking. Then visual proof. Then your irresistible offer. Before long, you'll be creating ads that consistently score 8-10 out of 10—ads that drive real revenue at scale.
Ready to implement a proven video ad system for your brand? Get started with our comprehensive direct response framework and join brands creating winning ads consistently.
Join The Dark Side Of Video Ads

